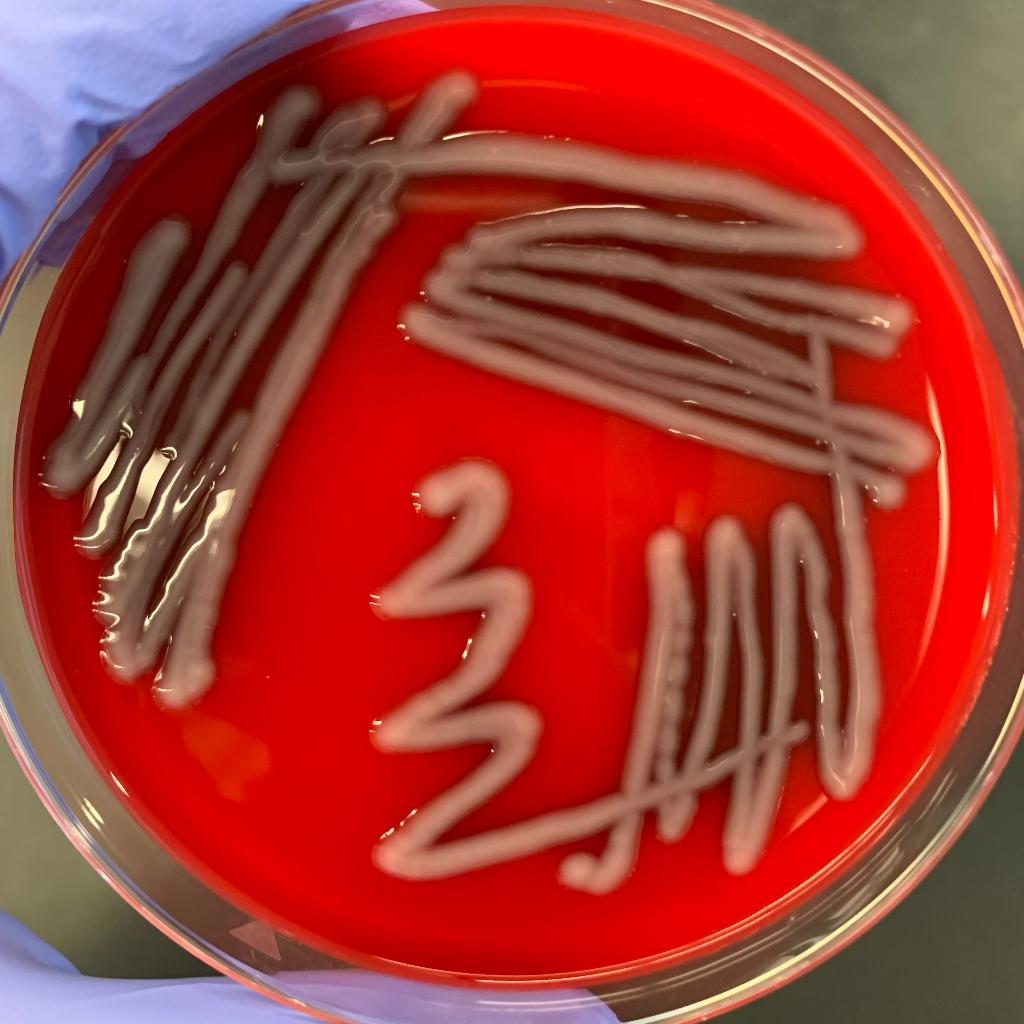

What Does No Bap Mean - He lost the bap meaning he got angry. ( british, ireland, slang, chiefly in the plural) a woman's breast. A round, soft form of bread that is usually smaller than a loaf: Mrs dudley came bouncing back, hand swinging, big. Web no cap is a way gen z makes fun of millennials who lie or are dishonest. Just like no cap, the term is very similar to the phrase lowkey. 2014, kelly creighton, the bones of it: Get the no bap mug. Web what does bap mean in british slang? Learn more about other popular gen z terms and their meanings, such as cheugy, drip, sheesh and more.
A round, soft form of bread…. This is a term that was created by bloods fueled by their hatred for the crips. ( british, ireland, slang, chiefly in the plural) a woman's breast. It conveys a sense of authenticity and truthfulness, rejecting any falsehoods or pretenses. Aye, that shit look fye, no bap !! no bap, i'm not really feeling it today. 2014, kelly creighton, the bones of it: “that’s bap, you didn’t wish me happy birthday.” bap in songs: It is a short form of no lie, a word that has a long history in african american vernacular english (aave). ( ireland, belfast, slang) the head. Web what does bap mean in british slang? Web bap (plural baps) a soft bread roll, originally from scotland. He lost the bap meaning he got angry. No cap but replacing the c with b. Get the no bap mug. Just like no cap, the term is very similar to the phrase lowkey. Mrs dudley came bouncing back, hand swinging, big. A round, soft form of bread that is usually smaller than a loaf: Web what does the term “no bap” mean? Bapped, bappin’, bapper, no bap. In british slang, “bap” refers to a type of bread roll or bun that is commonly used in sandwiches or burgers.